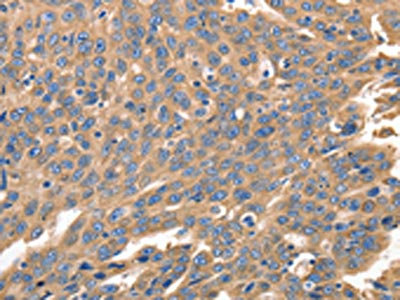

IRF1 Antibody
-
中文名稱:IRF1兔多克隆抗體
-
貨號:CSB-PA090613
-
規(guī)格:¥1100
-
圖片:
-
The image on the left is immunohistochemistry of paraffin-embedded Human liver cancer tissue using CSB-PA090613(IRF1 Antibody) at dilution 1/40, on the right is treated with synthetic peptide. (Original magnification: ×200)
-
The image on the left is immunohistochemistry of paraffin-embedded Human ovarian cancer tissue using CSB-PA090613(IRF1 Antibody) at dilution 1/40, on the right is treated with synthetic peptide. (Original magnification: ×200)
-
Gel: 12%SDS-PAGE, Lysate: 30 μg, Lane 1-2: NIH/3T3 cells, Jurkat cells, Primary antibody: CSB-PA090613(IRF1 Antibody) at dilution 1/750, Secondary antibody: Goat anti rabbit IgG at 1/8000 dilution, Exposure time: 1 minute
-
-
其他:
產品詳情
-
Uniprot No.:
-
基因名:
-
別名:Interferon regulatory factor 1 antibody; Interferon regulatory factor 1 isoform +I9 antibody; Interferon regulatory factor 1 isoform d78 antibody; Interferon regulatory factor 1 isoform delta4 antibody; Interferon regulatory factor 1 isoform delta7 antibody; IRF 1 antibody; IRF-1 antibody; IRF1 antibody; IRF1_HUMAN antibody; MAR antibody; MAR1 antibody
-
宿主:Rabbit
-
反應種屬:Human,Mouse,Rat
-
免疫原:Synthetic peptide of Human IRF1
-
免疫原種屬:Homo sapiens (Human)
-
標記方式:Non-conjugated
-
抗體亞型:IgG
-
純化方式:Antigen affinity purification
-
濃度:It differs from different batches. Please contact us to confirm it.
-
保存緩沖液:-20°C, pH7.4 PBS, 0.05% NaN3, 40% Glycerol
-
產品提供形式:Liquid
-
應用范圍:ELISA,WB,IHC
-
推薦稀釋比:
Application Recommended Dilution ELISA 1:2000-1:5000 WB 1:500-1:2000 IHC 1:50-1:200 -
Protocols:
-
儲存條件:Upon receipt, store at -20°C or -80°C. Avoid repeated freeze.
-
貨期:Basically, we can dispatch the products out in 1-3 working days after receiving your orders. Delivery time maybe differs from different purchasing way or location, please kindly consult your local distributors for specific delivery time.
-
用途:For Research Use Only. Not for use in diagnostic or therapeutic procedures.
相關產品
靶點詳情
-
功能:Transcriptional regulator which displays a remarkable functional diversity in the regulation of cellular responses. Regulates transcription of IFN and IFN-inducible genes, host response to viral and bacterial infections, regulation of many genes expressed during hematopoiesis, inflammation, immune responses and cell proliferation and differentiation, regulation of the cell cycle and induction of growth arrest and programmed cell death following DNA damage. Stimulates both innate and acquired immune responses through the activation of specific target genes and can act as a transcriptional activator and repressor regulating target genes by binding to an interferon-stimulated response element (ISRE) in their promoters. Competes with the transcriptional repressor ZBED2 for binding to a common consensus sequence in gene promoters. Its target genes for transcriptional activation activity include: genes involved in anti-viral response, such as IFN-alpha/beta, DDX58/RIG-I, TNFSF10/TRAIL, ZBP1, OAS1/2, PIAS1/GBP, EIF2AK2/PKR and RSAD2/viperin; antibacterial response, such as NOS2/INOS; anti-proliferative response, such as p53/TP53, LOX and CDKN1A; apoptosis, such as BBC3/PUMA, CASP1, CASP7 and CASP8; immune response, such as IL7, IL12A/B and IL15, PTGS2/COX2 and CYBB; DNA damage responses and DNA repair, such as POLQ/POLH; MHC class I expression, such as TAP1, PSMB9/LMP2, PSME1/PA28A, PSME2/PA28B and B2M and MHC class II expression, such as CIITA; metabolic enzymes, such as ACOD1/IRG1. Represses genes involved in anti-proliferative response, such as BIRC5/survivin, CCNB1, CCNE1, CDK1, CDK2 and CDK4 and in immune response, such as FOXP3, IL4, ANXA2 and TLR4. Stimulates p53/TP53-dependent transcription through enhanced recruitment of EP300 leading to increased acetylation of p53/TP53. Plays an important role in immune response directly affecting NK maturation and activity, macrophage production of IL12, Th1 development and maturation of CD8+ T-cells. Also implicated in the differentiation and maturation of dendritic cells and in the suppression of regulatory T (Treg) cells development. Acts as a tumor suppressor and plays a role not only in antagonism of tumor cell growth but also in stimulating an immune response against tumor cells.
-
基因功能參考文獻:
- IRF-1 regulates Rab27a transcription and extracellular vesicles secretion, leading to oxidized phospholipids activation of neutrophils and subsequent hepatic IR injury PMID: 29059701
- Down-regulation of interferon regulatory factor 1 gene expression in hepatitis B virus patients without rejection emphasized counteraction between hepatitis B virus replication and interferon regulatory factor 1 production. On the other hand, interferon regulatory factor 1 gene overexpression in patients with rejection may result in inflammatory reactions and ischemic-reperfusion injury. PMID: 27310137
- IRF-1 polymorphisms influence the risk for childhood allergic asthma being associated with increased pro-inflammatory gene regulation. PMID: 29047170
- IRF1 served as tumor suppressor in the regulation of cholangiocarcinoma cells proliferation, cell cycle, migration and invasion PMID: 29107934
- this study shows that IRF-1 is a regulator of lipopolysaccharide -induced endothelial proinflammatory activation PMID: 28658674
- These results revealed that IRF-1 is involved in the IFN-inducible expression of Nmi. PMID: 28913576
- our results indicated that IL-1beta treatment resulted in a significant increase in expression of the transcriptional factor interferon regulatory factor-1 (IRF-1) at both the mRNA and protein levels, which was significantly ameliorated by treatment with Nebivolol. The combination of these findings suggests that Nebivolol can potentially be applied in human osteoarthritis treatment PMID: 28512729
- The authors observe that IRF1 expression is mediated by ZEB1 de-repression, and the study demonstrates how airway remodelling/fibrosis is associated with a defective mucosal antiviral response through ZEB1-initiated epigenetic silencing in respiratory virus infection. PMID: 28581456
- These unprecedented data suggest that IRF1 and NF-kappaB orchestrate the TLR4-primed immunomodulatory response of hMSCs and that this response also involves the PI3K pathway. PMID: 27444640
- Zinc is capable of ameliorating the allogeneic immune reaction by enhancement of antigen-specific iTreg cells due to modulation of essential molecular targets by upregulation of Foxp3 and KLF-10 and downregulation of IRF-1. PMID: 27260002
- As a measure of PD-L1 expression capability, IRF-1 expression may be a more valuable predictive biomarker for anti-PD-1 therapy than PD-L1 itself. PMID: 28331615
- Upregulation of IRF1 in human adipocytes leads to phenotypes associated with obesity-related inflammation. PMID: 28416283
- Regulation of transcriptional activators by DNA-binding domain (DBD) ubiquitination has shown that, when attached to the DBD of either p53 or IRF-1, ubiquitin is orientated towards, and makes contact with, the DNA. PMID: 28362432
- In SK-Hep1 cells, an increase in apoptosis and decrease in autophagy were observed after IFN-gamma stimulation, which was accompanied with increasing IRF-1 levels. PMID: 27191889
- HNP1 upregulation of cytokine expression in pDCs was inhibited by blockade of NF-kappaB activation or knockdown of IRF1, demonstrating the importance of these two signaling events in HNP1-induced pDC activation. PMID: 27031443
- Data show that the Japanese encephalitis virus (JEV)-induced expression of miR-301a led to inhibition of the production of the transcription factor IFN regulatory factor 1 (IRF1) and the signaling protein suppressor of cytokine signaling 5 (SOCS5). PMID: 28196914
- A comprehensive mass spectrometric analysis identified interferon regulatory factor 1 (IRF1) as a key transcription factor in growth arrest of LNCaP-mTOR. PMID: 28905415
- our data provide an important insight into STING-mediated induction of type I and III IFNs and subsequent antiviral signaling pathways that regulate VZV replication in human dermal cells. PMID: 28647346
- IFN regulatory factor 1 effectively inhibits hepatitis E virus replication through the activation of the JAK-STAT pathway PMID: 27328944
- B. abortus lipoproteins via IL-6 inhibit the expression of IFN regulatory factor 1 (IRF-1), a critical regulatory transcription factor for CIITA induction. PMID: 27765819
- STAT1 and IRF1 collaborate to induce interferon-gamma stimulated genes (ISGs), but the extent to which they act alone or together is unclear.This study provides strong evidence for widespread cooperation between STAT1 and IRF1 at ISGs, and suggests that in silico predictions reliably predict the effect of nucleotide variants on binding in vivo. PMID: 28274199
- aimed to determine the role of Treg cells and IRF-1 in MDS PMID: 28113084
- Tat exploited the cellular HDM2 (human double minute 2 protein) ubiquitin ligase to accelerate IRF-1 proteasome-mediated degradation, resulting in a quenching of IRF-1 transcriptional activity during HIV-1 infection. PMID: 27795392
- Leading to a STAT1-IRF1 controlled upregulation of TLR3 expression in macrophages. PMID: 27940139
- Regulatory elements for both IRF-1 (-1019 to -1016) and CREB (-1198 to -1195), specific to the distal THBS1 promoter, were required for leptin-induced TSP-1 transcription. PMID: 27281481
- Inflammation-driven IRF1 and NF-kappaB activity promotes ERVK reactivation. PMID: 27512062
- MiR-23a downregulates the expression of IRF-1 in HCC cells. PMID: 27279136
- the interactions of IRF1, IFN-beta and IRF5 are involved in the M1 polarization of macrophages and have antitumor functions. PMID: 27176664
- rs56288038 (C/G) in IRF-1 3'UTR acted as a promotion factor in gastric cancer development through enhancing the regulatory role of miR-502-5p in IRF-1 expression. PMID: 27866197
- An IRF-1 shorter splicing transcript has been identified in acute promyelocytic leukemia cells dispalying similar transactivation activity to the full length transcript. PMID: 28039033
- Data suggest that interferon beta (IFN-beta) might be involved in modulating the expressions of interferon regulatory factor 1 (IRF1) and interferon regulatory factor-5 protein (IRF5) as well as maintaining the M1 polarization status and its function. PMID: 27363262
- IRF1 upregulation in fetal membranes and myometrium after term labor indicates a proinflammatory role for IRF1 in human parturition. IRF1 is involved in TLR- and cytokine-mediated signaling in human myometrium. PMID: 26674566
- 5AZ had a protective effect after MI by potentiation of IRF1 sumoylation and is suggested as a novel therapeutic intervention for cardiac repair. PMID: 26510961
- IRF1 is a transcriptional regulator of IRG1 in human macrophages. PMID: 26872335
- Data show that ectopic expression of interferon regulatory factor 1 (IRF-1) reduces NF-kappa B activity and suppresses TNF receptor-associated factor 2 (TRAF2) and inhibitor of apoptosis 1 protein (cIAP1) expression in breast cancer cells. PMID: 26011589
- Gene expression meta-analysis reveals immune response convergence on the IFNgamma-STAT1-IRF1 axis and adaptive immune resistance mechanisms in lymphoma PMID: 26362649
- The present data demonstrate that IRF-1 could effectively promote the immune maturation and function of dendritic cells in ACS Acute Coronary Syndrome patients. PMID: 25997853
- IRF1, a transcription factor, regulates miR-203 transcription by binding to the miR-203 promoter. PMID: 25658920
- Single nucleotide polymorphisms in RBPJ, IL1R1, REV3L, TRAF3IP2, IRF1 and ICOS showed association with rheumatoid arthritis in black South Africans. PMID: 25014791
- IRF1 directly interacts with chromatin modifying enzymes, supporting a model where recruitment to specific target genes is mediated in part by IRF1. PMID: 25611806
- IRF1 re-expression in human cancer cells causes cells to become resistant to infection by the oncolytic vesicular stomatitis virus strain. PMID: 25347735
- IRF1 is a dual regulator of BV6-induced apoptosis and inflammatory cytokine secretion. PMID: 25501823
- IRF-1 promotes LTx I/R injury via hepatocyte IL-15/IL-15Ralpha production and suggest that targeting IRF-1 and IL-15/IL-15Ralpha may be effective in reducing I/R injury associated with LTx. PMID: 25964490
- IRF-1 regulates the transcription of target genes which play essential roles in various physiological and pathological processes, including viral infection, tumor immune surveillance, pro-inflammatory injury, development of immune system. (Review) PMID: 25312803
- silencing IRF1 promoted autophagy by increasing BECN1 and blunting IGF1 receptor and mTOR survival signaling PMID: 25576084
- IRF-1 is an important signaling protein in the interferon pathway. It not only activates gene expression as a transcription factor, but may perpetuate disease by leading to a dysregulated epigenome PMID: 25418955
- Data suggest that interferon regulatory factors 1 and 2 (IRF1 and IRF2) may serve as potential targets of therapy. PMID: 24632547
- Data indicate that the interferon regulatory factor (IRF1) promotion was observed in cancer cell lines treated with different MEK inhibitors or with RNAi oligonucleotides against extracellular signal-regulated kinases (ERK1/2). PMID: 25497010
- A positive feedback loop between IRF1 and miR-29b may contribute to the sensitivity of colorectal cancer cells to IFN-gamma by repressing IGF1. PMID: 25592039
- The novel AS regulatory activities attributed to IRF-1 indicate that the IFN-gamma response involves a global change in both gene transcription and AS in breast epithelial cells. PMID: 24650050
顯示更多
收起更多
-
相關疾?。?/div>Gastric cancer (GASC)亞細胞定位:Nucleus. Cytoplasm.蛋白家族:IRF family數據庫鏈接:
Most popular with customers
-
-
YWHAB Recombinant Monoclonal Antibody
Applications: ELISA, WB, IHC, IF, FC
Species Reactivity: Human, Mouse, Rat
-
Phospho-YAP1 (S127) Recombinant Monoclonal Antibody
Applications: ELISA, WB, IHC
Species Reactivity: Human
-
-
-
-
-